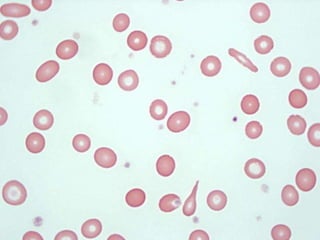

This document discusses trace elements and minerals that are essential for human beings, focusing on iron. It provides details on:
1. Iron is an essential trace element required in small amounts. It is important for transporting oxygen via hemoglobin and myoglobin and is involved in oxidative reactions and tissue respiration as part of enzymes.
2. Iron is absorbed in the small intestine and transported via transferrin in plasma. It is stored in liver, spleen and bone marrow bound to protein ferritin or hemosiderin. Iron balance is maintained through intestinal absorption to replace losses.
3. Iron deficiency is common worldwide and can result from inadequate dietary intake or malabsorption. Good dietary sources include meat, fish,